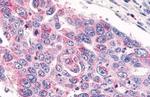
GPR26 Antibody in Immunohistochemistry (Paraffin) (IHC (P))

Search
Invitrogen
GPR26 Polyclonal Antibody
{{$productOrderCtrl.translations['antibody.pdp.commerceCard.promotion.promotions']}}
{{$productOrderCtrl.translations['antibody.pdp.commerceCard.promotion.viewpromo']}}
{{$productOrderCtrl.translations['antibody.pdp.commerceCard.promotion.promocode']}}: {{promo.promoCode}} {{promo.promoTitle}} {{promo.promoDescription}}. {{$productOrderCtrl.translations['antibody.pdp.commerceCard.promotion.learnmore']}}
产品信息
PA1-20409
宿主/亚型
分类
类型
抗原
偶联物
形式
浓度
规格
保存条件
运输条件
RRID
产品详细信息
PA1-20409 detects G Protein-Coupled Receptor GPR26 in human samples.
靶标信息
The G-protein-coupled receptor (GPCR) superfamily is comprised of an estimated 600-1,000 members and is the largest known class of molecular targets with proven therapeutic value. GPR26 is a brain-specific orphan GPCR with a significant level of constitutive activity. Its effect is mediated by G(s)-alpha protein that stimulate adenylate cyclase, resulting in an elevation of intracellular cAMP. In the CNS, the highest GPR26 expression is in the amygdala, hippocampus and thalamus. Weak expression is detected in testis. GPR26 is down-regulated in glioblastoma. Depletion of GPR26 has been shown to increase fat storage in C. elegans, whereas GPR26 deficiency in the hypothalamus is associated with high genetic susceptibility to the onset of obesity in mice. GPR26 deficiency also causes metabolic complications commonly associated with obesity, including glucose intolerance, hyperinsulinemia, and dyslipidemia.
仅用于科研。不用于诊断过程。未经明确授权不得转售。